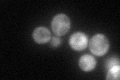
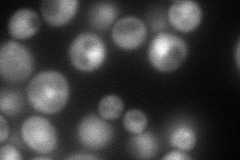

View description
Topoisomerase II-associated deadenylation-dependent mRNA-decapping factor; also required for faithful chromosome transmission, maintenance of rDNA locus stability, and protection of mRNA 3'-UTRs from trimming; functionally linked to Pab1p
Localization:
Intensity:
Fold change:
Significance:
-
C’ GFP library in SD
cytosol59.53 -
N' NOP1pr-GFP in SD
cytosol,nucleus114.597 -
N' TEF2pr-mCherry in SD

nucleus51.9229 -
N' NATIVEpr-GFP in SD

cytosol57.2623 -
N' TEF2pr-VC and Cyto-VN in SD

cytosol39.0457 -
C’ GFP library in SD+DTT

cytosol54.020.9No -
C’ GFP library in SD+H2O2

punctate,cytosolN/AN/AYes -
C’ GFP library in Starvation Media

punctateN/AN/AYes -
C’ GFP library on the background of Pup2-DaMP

N/A -
C’ GFP library on the background of CCT mutant

N/A0N/AYes
